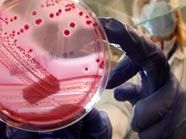

Die Frau stammt aus dem von EHEC besonders betroffenen Bundesland Niedersachsen und war bereits mit entsprechenden Symptomen eingereist, berichtete Thomas Kvicala, Sprecher von Gesundheitsminister Alois Stöger.
Es dürfe sich wohl um eine Infektion mit den aggressiven EHEC-Bakterien (HUS) handeln, da die Nieren der Patientin betroffen sind. Klarheit werden aber erst die weitergehenden Untersuchungen des Keims ergeben. “Mittlerweile ist sie auf dem Weg der Besserung, sie ist ansprechbar”, betonte Kvicala.
Zeitung: Mögliche EHEC-Quelle in Lübeck
Den “Lübecker Nachrichten” zufolge hatten sich 17 Menschen in der Gaststätte mit EHEC infiziert. “Die Lieferantenkette kann möglicherweise den entscheidenden Hinweis geben, wie der Erreger in Umlauf gekommen ist”, zitierte das Blatt Werner Solbach, Mikrobiologe am Universitätsklinikum Schleswig-Holstein. Zuvor hatte die “Süddeutsche Zeitung” auf ihrem Online-Portal jetzt.de berichtet, dass sich 34 Frauen von der Deutschen Steuergewerkschaft vom 12. bis 14. Mai in Lübeck getroffen hatten. Mindestens acht von ihnen hätten sich den EHEC-Keim zugezogen, von denen eine Frau gestorben sei.
Verseuchtes Gemüse nicht der Auslöser
Auf der Suche nach der Ursache für die rasante Ausbreitung des Darmkeims haben unterdessen italienische Wissenschaftler verseuchtes Gemüse ausgeschlossen. Tests hätten ergeben, dass kontaminiertes Gemüse nicht der Grund für die massenhaften Infektionen sei, erklärte das EU-Referenzlabor für E-Coli-Bakterien in Rom am Freitag. “Panikmache zum Konsum von Gemüse ist nicht gerechtfertigt”, erklärte das Labor, das zum italienischen Gesundheitsinstitut ISS gehört. Die bestehenden Hygienenormen zur Lebensmittelsicherheit reichten aus, um Infektionen zu vermeiden.
Das Robert-Koch-Institut und das Bundesinstitut für Risikobewertung erklärten dagegen am Freitagabend, es werde weiterhin empfohlen, “vorsorglich Tomaten, Salatgurken und Blattsalate nicht roh zu verzehren”. Diese Warnhinweise würden durch die Ergebnisse von neuen epidemiologischen Studien des Robert-Koch-Instituts bestätigt. Eine Befragung von Erkrankten habe ergeben, dass 95 Prozent von ihnen mindestens eine der drei Gemüsearten verzehrt hatten. Die Warnung gelte vor allem in Norddeutschland.
EHEC-Keim – WHO-Experte: Fleisch verdächtiger als Gemüse
Wäre Rindfleisch die Quelle für den gefährlichen Keim, könnte das auch mit der massiv Beigabe von Antibiotika in Tierfutter zu tun haben, sagte er. Dadurch seien die Bakterien zusätzlich resistent geworden.
Laut WHO ist EHEC bisher in zwölf Ländern aufgetreten. Infektionen gibt es demnach außer in Deutschland auch in Österreich, Tschechien, Dänemark, Frankreich, den Niederlanden, Norwegen, Spanien, Schweden, Schweiz, Großbritannien und den USA. Von den meisten Patienten wisse man, dass sie zuvor in Deutschland waren. In Italien ist bisher noch kein Fall bekanntgeworden
APA
Du hast einen Hinweis für uns? Oder einen Insider-Tipp, was bei dir in der Gegend gerade passiert? Dann melde dich bei uns, damit wir darüber berichten können.
Wir gehen allen Hinweisen nach, die wir erhalten. Und damit wir schon einen Vorgeschmack und einen guten Überblick bekommen, freuen wir uns über Fotos, Videos oder Texte. Einfach das Formular unten ausfüllen und schon landet dein Tipp bei uns in der Redaktion.
Alternativ kannst du uns direkt über WhatsApp kontaktieren:  Zum WhatsApp Chat
Herzlichen Dank für deine Zusendung.